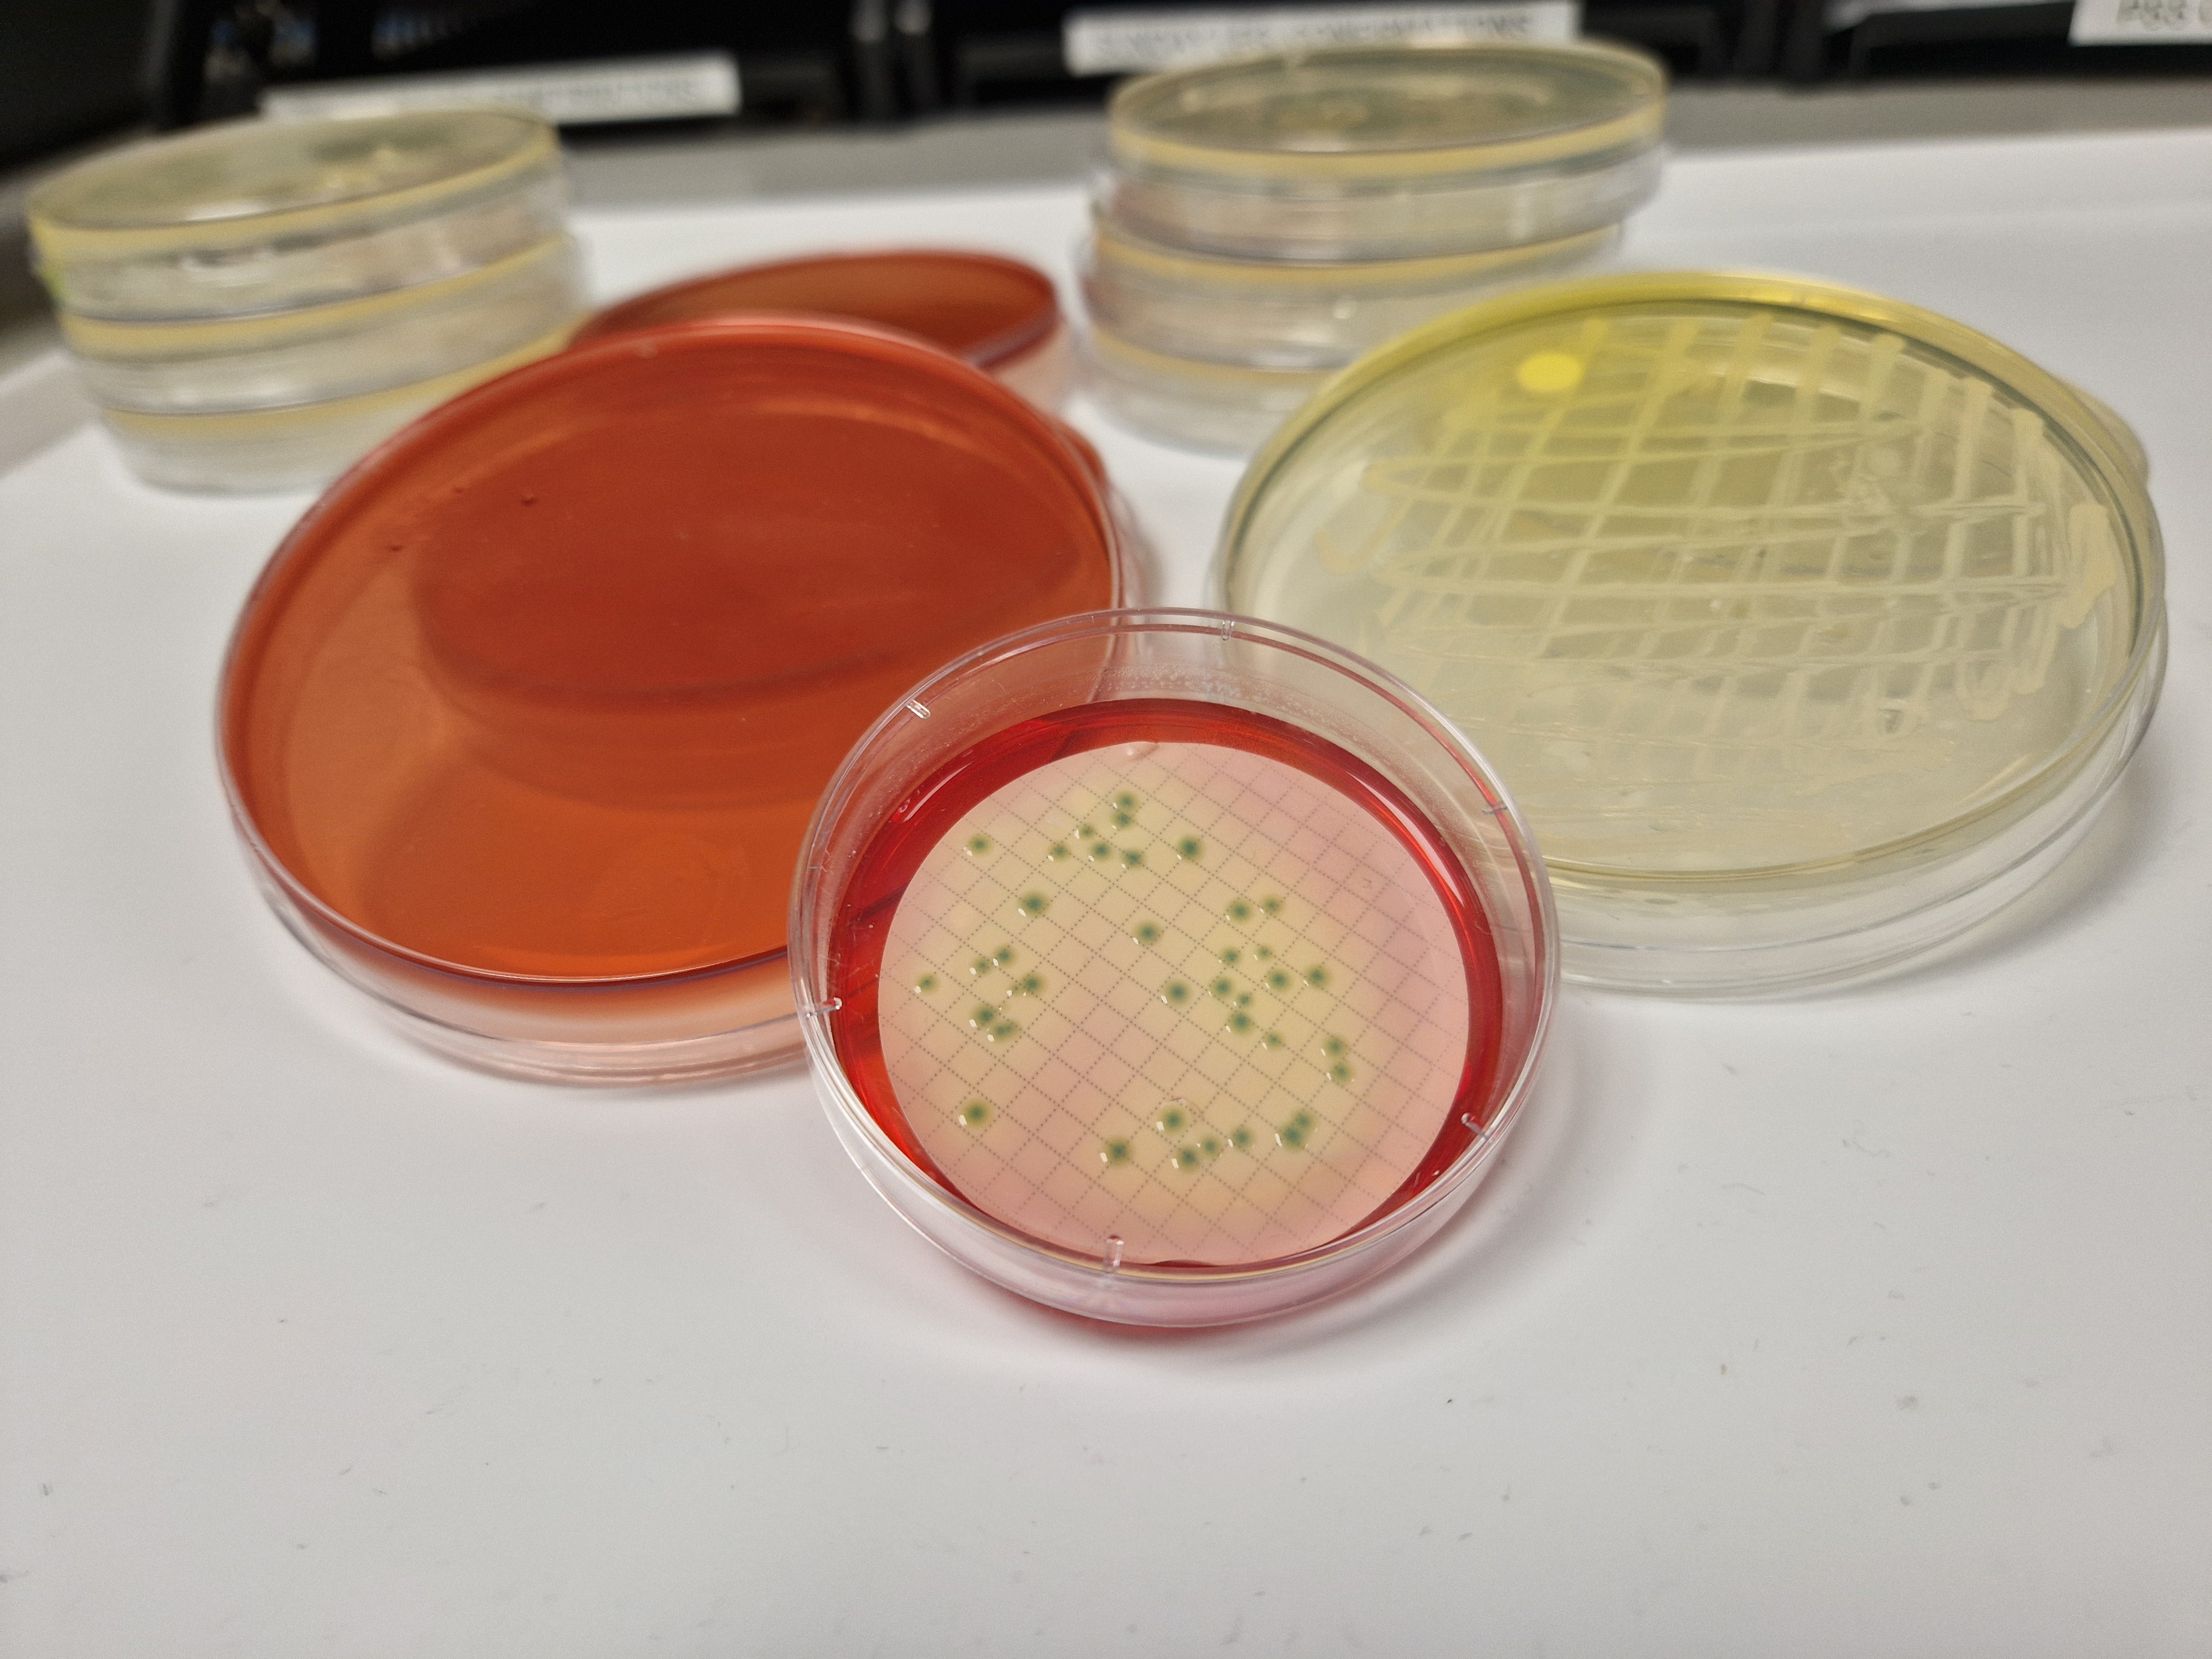
MLGA agar

Analysing 100 mL of water for Coliforms and Escherichia coli (E. coli) using Membrane Lactose Glucuronide Agar (MLGA) is crucial for assessing microbial water quality. This analysis helps determine if water is safe for drinking, recreational use, or industrial applications.
Analysis Reasons
The key reasons for this analysis include:
Public Health Protection
E. coli is an indicator of faecal contamination, and its presence suggests possible pathogens in the water. Klebsiella species, while not always faecal in origin, can be opportunistic pathogens.
Regulatory Compliance
Many water quality standards (e.g., WHO, EPA, UK DWI, EU Drinking Water Directive) require monitoring of E. coli in a 100 mL sample to confirm compliance with microbiological safety standards.
Early Contamination Detection
Rapid detection helps in identifying pollution sources, such as sewage leaks or agricultural runoff.
Monitoring Water Treatment Efficiency
Checking for bacterial presence ensures that disinfection and filtration processes are effective.
Filtration Process and Enumeration of Coliforms and E. coli on MLGA
1. Sample Collection
Collect 100 mL of water in a sterile container with sodium thiosulfate (if chlorinated water).
Store and transport at 4°C and process within 24 hours for accurate results.
2. Filtration Process
Membrane Filtration Method is used as per ISO 9308-1 standards and SCA Microbiology of Drinking Water Part 4.
A 0.45 µm pore size membrane filter is placed on a filtration unit.
The 100 mL water sample is vacuum-filtered, trapping bacteria on the membrane.
The filter is then transferred onto an MLGA agar plate.
3. Incubation
Plates are incubated for 18–24 hours for total coliforms and for E. coli identification.
Incubation temperature may vary from 30 to 37°C.
4. Colony Enumeration and Interpretation
On MLGA agar:
E. coli colonies appear dark green (due to β-glucuronidase activity).
Klebsiella and other coliforms appear yellow (lactose fermentation).
Colonies are counted using CFU/100 mL units.
If no E. coli is detected in 100 mL, and the water meets drinking water standards (0 CFU/100 mL required by WHO, EPA, and UK DWI), it is considered safe.
The presence of Klebsiella and other coliforms indicates potential contamination from faecal sources, regrowth, or biofilm formation in pipes.
This method provides a reliable, sensitive, and rapid assessment of microbial contamination in water, ensuring public health and environmental safety.
Get in touch
To learn more about our microbiology and chemistry testing services and how we can help you, contact the CTS Water Microbiology team today!